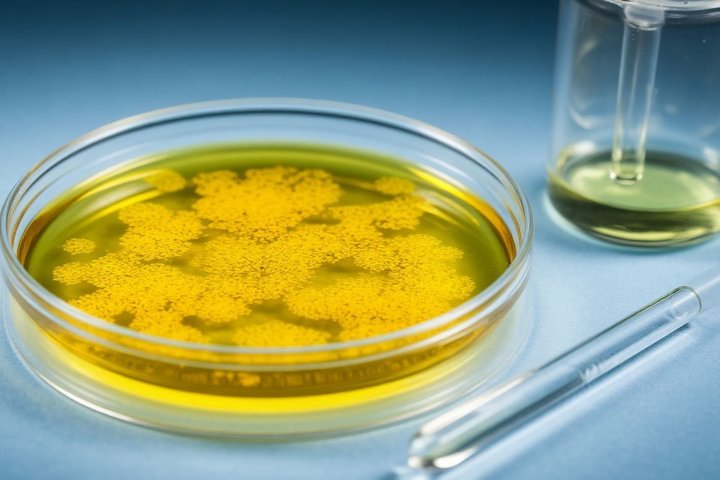

Искусственная сиреневая кровь, растворимый пластик, космический «мегасалют»
Интересные новости науки за неделю со 2 по 8 июня

Искусственная сиреневая кровь устроит революцию в медицине к 2030 году?
Японские ученые из Медицинского университета Нары начали клинические исследования искусственной крови. В отличие от донорской крови, жизнеспособной всего месяц, искусственный аналог хранится до двух лет при комнатной температуре и до 5 лет в холодильнике. Кроме того, синтетическая кровь универсальна, подходит человеку с любой группой. А еще она фиолетового цвета.
Технология, которую разработал профессор Хироми Сакаи и его команда в Наре, заключается в том, что из просроченной донорской крови извлекли гемоглобин и запечатали его в «капсулу» — вирусоустойчивую оболочку. Получились везикулы, которые являют собой уменьшенную модель эритроцита (они в 30 раз меньше настоящих красных кровяных телец).
Масса, содержащая эти «эритроциты», с 2022 года в рамках клинических испытаний вводится добровольцам. Первые инъекции в возрастающих количествах (до 100 мл) получили три группы — по четыре здоровых мужчины. Значительных изменений жизненно важных показателей не произошло. Теперь исследования расширяются — с марта добровольцам вводятся от 100 до 400 мл раствора искусственных клеток крови. И если будет доказана ее безопасность и эффективность, к 2030 году ее применение уже удастся внедрить широко.

В научном мире эта новость обсуждается как «тихая революция» в мире медицины. Ведь если у японцев все получится, травматология, хирургия, родовспоможение по всему миру преобразятся радикально. Напомним: сегодня, чтобы сделать обильную гемотрансфузию, нужно, чтобы в наличии была донорская кровь нужной группы и подходящая по резус-фактору. А донорской крови всегда недостаточно. Крови от универсальных доноров (I группа, отрицательный резус-фактор), которая подходит всем, на всех, к сожалению, не хватает. Синтетическая «кровь», которую придумали японцы, не зависит от группы крови реципиента. А еще ее срок годности в 24 раза больше, чем у всех остальных доступных на сегодня вариантов. Если способ докажет свою эффективность — искусственная кровь может стать самым крупным достижением медицины с момента открытия антибиотиков.
Пластик научились растворять в морской воде
Еще одно хитроумное изобретение японских ученых мы приготовили в честь Всемирного дня окружающей среды, который отмечался 5 июня на этой неделе. В Центре исследований новых веществ RIKEN и Токийском университете разработали пластик, который способен полностью разлагаться в морской воде. Растворение занимает несколько часов. Эту технологию исследователи предлагают использовать, чтобы решить проблему глобального загрязнения океана пластиком.
С биоразлагаемыми пластиками ученые экспериментируют уже давно, и в этом деле уже достигнуты немалые успехи. Японская научная группа решила сосредоточиться на «океаноразлагаемости». И продемонстрировала в лаборатории, как небольшой кусочек материала, подобного пластику, исчезает в контейнере с соленой водой после часа перемешивания.
По словам ученым, по прочности новый материал не уступает пластику, сделанному на основе нефти, а на исходные компоненты разлагается под воздействием соли. Этими исходными компонентами служат гексаметафосфат натрия (который, используется и как пищевая добавка) и мономеры на основе ионов гуанидина. Эти компоненты впоследствии дополнительно могут быть переработаны бактериями, которые живут в окружающей среде, а это позволит избежать накопления микропластика. Кстати, и в почве новый материал может разлагаться (ведь соль есть и в ней) — на полное исчезновение 5-сантиметрового кусочка должно потребоваться меньше 10 суток.

Планы по коммерциализации проекта пока не озвучены. Однако руководитель научной группы Такудзо Айда намекнул, что исследованием уже интересуются представители упаковочной отрасли. Ведь растущий кризис пластиковых отходов не спит: по прогнозам Программы ООН по окружающей среде, к 2040 году загрязнение пластиком утроится, и в мировой океан будет ежегодно сбрасываться 23—37 миллионов тонн отходов.
Новое оружие против супербактерий
На этой неделе вышло исследование, в котором описан новый препарат антимикробного действия, который активен против двух штаммов болезнетворных бактерий — золотистого стафилококка и одного из энтерококков. Это два грамположительных патогена, которые с высокой вероятностью становятся устойчивыми к известным антибиотиком и вызывают опасные внутри— и внебольничные инфекции. Антибиотикорезистентность, по данным ВОЗ, напрямую становится причиной более чем миллиона смертей в год. Еще 35 миллионов смертей вызываются ею косвенно. Штаммы прокариотов, которые в процессе быстрой эволюции наращивают «броню» против препаратов, в обиходе называют супербактериями.
И вот — новая попытка найти лекарство против супербактерий. Новое вещество называется инфузид, изготовлено оно на основе гидразонов (биологически активных веществ, которые способны синтезироваться в лаборатории). Над его созданием работали ученые из Университета Тулузы (Франция) и Института исследования медикаментов Лакхнау (Индия). Новый препарат в лабораторных условиях и в эксперименте на мышах показал высокую активность против стафилококка и стрептококка.
Инфузид убивает бактерии способами, отличными от тех, что используются в других противомикробных препаратах — а значит, бактерии еще не успели выработать резистентность к этим способам. В лабораторных исследованиях антимикробное действие инфузида сравнили с ванкомицином (мощный антибиотик, стандарт лечения резистентных инфекций). Выяснилось, что новый препарат уменьшает размер бактериальных колоний быстрее и надежнее. Эффективно показало себя это вещество и на мышах — колония антибиотикорезистентного золотистого стафилококка на коже у мышек сильно пострадала.
Важно, что исследователи синтезировали соединение так, чтобы для его производства не потребовалось применять растворители. Химическая реакция проста и использование ее позволит легко наладить масштабное производство.
В 8 миллиардах световых лет от Земли зафиксировали самые мощные вспышки во Вселенной
Некоторые объекты в космосе по разным причинам становятся в разы ярче, чем обычно. Такие объекты называют транзиентами. Такие вспышки случаются по разным причинам. Например, если происходит вспышка сверхновой, или же сливаются воедино две нейтронные звезды, или же нейтронная звезда втягивается черной дырой. Астрономы, как правило, хорошо понимают по характеру излучения, что происходит в каждом отдельном случае.
Но недавно астрономы из Гавайского университета (США) зафиксировали три вспышки, которые классифицировать пока не удалось. Вспышки нашли с помощью космической обсерватории Gaia и наземного телескопа Zwicky Transient Facility. Все три экстремальных транзиента произошли в разных галактиках — настолько далеких, что свет от них летел примерно 8 миллиардов лет. То есть таким образом мы наблюдаем события, которые произошли задолго до рождения Земли.
У этих транзиентов чудовищная мощность — до сих пор земные астрономы никогда не фиксировали космических вспышек, в которых выделялось бы столько энергии. По этому параметру они уложили на лопатки не только коллапсирующие звезды, но и вообще все известные до сих пор транзиенты. Во время событий преобладало рентгеновское излучение. А еще объекты оставались яркими очень долго. Находясь внутри этих галактик, мы наблюдали бы транзиенты 171, 155 и 205 дней. Но в реальности обсерватории фиксировали их почти вдвое дольше — расширение Вселенной создает такой «замедленный» эффект, когда астрономы наблюдают глубокий космос. Для этих трех событий даже придумали новый термин: Extreme Nuclear Transients (экстремальные ядерные транзиенты).
Интересно еще то, что все три «взрыва» произошли очень близко к центру своих галактик. Поэтому ученые, пытаясь объяснить, как они получились, предполагают, что сверхмассивная черная дыра в центре каждой такой галактики притянула к себе звезду, полностью разрушила ее — и получились брызги плазмы, усеявшие космос. Такой процесс называется приливным разрушением.

Уничтоженные звезды, по предположениям ученых, были втрое тяжелее Солнца, а черные дыры, которые разорвали их в плазменные клочья, содержали в себе массу в 100 миллионов солнц. (Если вы не знали: черная дыра в центре нашей галактики, Млечного Пути, содержит всего 4 миллиона солнечных масс).
По следам ДНК в воздухе можно определить, кто здесь проходил
За одну неделю в апреле 2023 года территория нацпарка Вашингтон-Оукс-Гарденс во Флориде была оживленной. Пробежала рысь — она преследовала серых белок. По подлеску скользнула гремучая змея. Еще здесь побывали летучая мышь, скопа, различные насекомые… и люди с азиатскими, африканскими и европейскими корнями.
Ни одного из этих существ ученые из Университета Флориды не видели напрямую. Все это показали пробы ДНК, взятые прямо из воздуха! Передовые технологии анализа ДНК позволяют теперь находить доказательства пребывания их обладателей в каком-либо месте. Исследователи описали свои методы в статье и показали: изучая ДНК из воздуха, можно собрать данные о биоразнообразии, распространении болезнетворных микроорганизмов и инвазивных видов. Но поскольку в воздухе носится и генетический материал человека, поднимаются и этические вопросы о том, что в недобросовестных руках этот инструмент может принести вред.
В последнее десятилетие ученые уже не раз обращались к ДНК, которую живые организмы оставляют в воде, воздухе и грязи. Ее окрестили E-DNA — Environmental DNA, или ДНК окружающей среды. К примеру, этот подход уже позволяет изучать вирусы животных, которые могли бы теоретически спровоцировать следующую пандемию. А еще по e-ДНК проводили инвентаризацию видов в океане и на суше.
До сих пор анализ «ДНК окружающей среды» требовал нескольких недель для обработки данных. А увидеть по нему можно было лишь малую часть огромного количества участков ДНК в капле воды. Новое исследование использует иной подход — сочетание метода дробовика (или дробного секвенирования) и нанопорового секвенирования. В прошлом «метод дробовика» был слишком дорогим и трудоемким для рутинной обработки образцов окружающей среды. Но недавние достижения снизили затраты и позволили получать результаты всего за два дня. Устройство для анализа размером меньше пачки сигарет и его можно спокойно подключать к ноутбуку.

Ученые утверждают, что это уже экономически эффективно, осуществимо и позволяет отвечать на множество новых вопросов. Дробное секвенирование ДНК обычно используется для поиска микроорганизмов. Однако исследователи из Флориды, как видим, смогли выделить из флоридского воздуха достаточно генетических маркеров рыси. А еще собрали достаточно длинные участки человеческой ДНК, которые позволили определить даже историческое происхождение ее хозяев.
Эта работа знаменует собой шаг к мечте о доступном способе получения полной картины всей ДНК, присутствующей в одном месте.